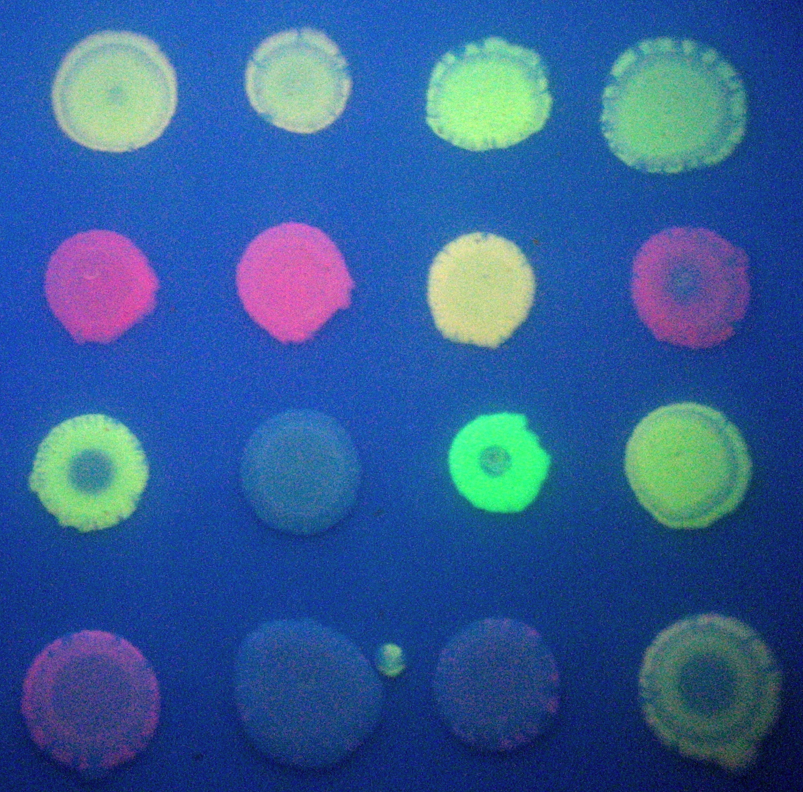

What is Synthetic Biology?
Synthetic Biology uses molecular methods to construct DNA-based devices that perform new functions.
Synthetic biologists:
Synthetic Biology is divided into two areas:

Investigators at the J. Craig Venter Institute are engineering
whole genomes and "rebooting" cells as bioengineering chassis.
See
genome synthesis paper here.
Genome
transplantation paper here.
Synthetic biologists at UT Austin developed
the world's first bacterial photography. Shine light on the cells and they
turn black.
Read profile
of artists working with synthetic biologists.
Synthetic Biology is Win-Win Research

Engineered E. coli pulse lights on and off as designed.
Read about the Repressilator.
Split GFP and RFP produced a variety of colors, more than were expected. Read
more.
How is Synthetic Biology Different? Synthetic
biology uses four principles not typically found in genetics, genomics, or
molecular biology: abstraction, modularity, standardization, and design
and modeling.
Abstraction: don't focus on the DNA sequences, but think of the parts as units in a circuit diagram. Abstraction means you can used parts/devices/systems without having to worry about how they work. DNA is used to make parts. Parts are assembled into devices. Devices are connected to make systems. Read more.

Circuit diagram for membrane potential.
Modularity: parts, devices and systems can be connected as self-contained units and combined in any combination you want.

Modular AND logic gate built by Chris
Anderson at UC Berkeley.
Read
the paper.
Read about logic gates.
Standardization: by
agreement, many aspects of the designs are standardized to improve overall
function. One example is the standard way parts, devices, and systems are
connected so that new designs will fit with old designs. An everyday example
is that all light bulbs fit into any socket! 

BioBrick assembly allows users to connect each others parts, devices, and systems.
Read more.
Designing and modeling: before building, build a model and test the devices capacity. This not only improves design but tests basic biological assumptions that could be false.

Models of cellular chemotaxis by undergraduates at Bristol University, UK. Read
more.
BioBrick Registry of Standard Parts: http://partsregistry.org/Main_Page

Parts designed and built by undergraduates since 2004. Read more.
What is iGEM?
International Genetically Engineered Machines Jamboree/Competition. Gathering of the top synthetic biology students from around the world in a friendly competition to learn and share.
Do it yourself Biology (1 hour lecture by Natalie Kuldell and Reshma Shetty)


International Genetically Engineered Machines Jamboree/Competition 2008 photo.
Read More.
Additional Resources and Information
See a PowerPoint Slide Show that includes two research projects by undergraduates. The slide show also presents a new approach to introductory biology called Integrated Systems Biology as a way to improve undergraduate biology education that would better prepare students for biology in general and biology research in particular.
Read an open access Burnt Pancake Problem paper published by undergraduates. You can also read another open access paper by undergraduates addressing the Hamiltonian Path Problem.
Link to some papers about synthetic biology.
© Copyright 2011
Department of Biology, Davidson College, Davidson, NC 28035
Send comments, questions, and suggestions to: macampbell@davidson.edu